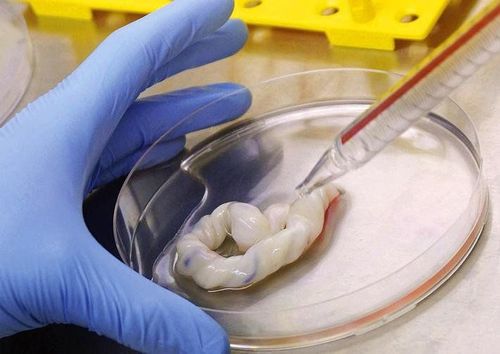

Lưu trữ tế bào gốc từ máu cuống rốn cho trẻ sơ sinh đang là chủ đề thu hút sự quan tâm đặc biệt từ đông đảo những ai sắp trở thành cha mẹ. Cách tiếp cận này mang lại nhiều lợi ích đáng kể cho cả trẻ em và các thành viên trong gia đình. Hãy theo dõi bài viết sau để hiểu chi tiết hơn về vấn đề này.
Bài viết này được viết dưới sự hướng dẫn chuyên môn của các bác sỹ thuộc Trung tâm Công nghệ cao Vinmec.
1. Máu cuống rốn là gì?
Máu cuống rốn, còn được gọi là máu dây rốn hoặc máu bánh nhau, là dòng máu chảy trong hệ tuần hoàn của thai nhi, đóng vai trò quan trọng trong việc cung cấp dưỡng chất cho sự phát triển của thai nhi trong tử cung của người mẹ. Đây là những "sợi dây" kết nối mẹ và con, mang trong mình các chất dinh dưỡng thiết yếu.
Sau khi sinh, một phần máu cuống rốn được lưu trữ trong dây rốn và bánh nhau của sản phụ. Máu này chứa nhiều loại tế bào gốc, đặc biệt là tế bào gốc tạo máu, đóng vai trò quan trọng trong việc bổ sung máu và tái tạo hệ miễn dịch.
Trước đây, dây rốn và bánh nhau thường bị loại bỏ do được coi là rác thải y tế. Tuy nhiên, hiện nay, với sự tiến bộ của nhiều phương pháp điều trị mới, máu từ dây rốn được thu thập, xử lý và lưu trữ để sử dụng trong điều trị cho người mang dây rốn đó hoặc các thành viên khác trong gia đình khi họ gặp vấn đề sức khỏe.
2. Tế bào gốc máu dây rốn có tác dụng gì?
Lưu trữ tế bào gốc máu cuống rốn được coi là một loại "bảo hiểm sinh học" cho trẻ em. Đối với một đứa trẻ, không ai có thể biết chắc chắn họ sẽ phải đối mặt với những bệnh lý gì trong tương lai, có thể là do yếu tố di truyền, môi trường, hoặc các bệnh liên quan đến máu và hệ miễn dịch.
Nếu lưu trữ tế bào gốc máu cuống rốn cho trẻ, chúng có thể hỗ trợ trong việc điều trị bệnh mà không gây ra các phản ứng miễn dịch đối với cơ thể. Khi sử dụng tế bào gốc từ chính bản thân mình, trẻ không cần phải dùng các loại thuốc ức chế miễn dịch để duy trì việc ghép tế bào.
Trong trường hợp gia đình cần sử dụng tế bào gốc để điều trị một bệnh, khả năng phù hợp giữa người bệnh và tế bào gốc từ máu dây rốn của trẻ sẽ cao hơn so với tế bào gốc từ nguồn không cùng huyết thống. Có ba nguồn chính của tế bào gốc: tủy xương, máu ngoại vi và máu cuống rốn. Điều này đặc biệt quan trọng trong việc chọn lựa tế bào gốc phù hợp nhất cho việc điều trị.
Tuy nhiên, do vấn đề phức tạp và chi phí cao của tế bào gốc từ tủy xương và máu ngoại vi, cũng như khả năng ghép gen không cao, việc ưu tiên lựa chọn máu cuống rốn là phù hợp hơn.

3. Máu cuống rốn chữa được những bệnh nào?
Lưu trữ máu cuống rốn để sử dụng trong quá trình cấy ghép tế bào gốc đã được chứng minh là có thể giúp điều trị nhiều bệnh lý nguy hiểm, bao gồm:
- Bệnh ác tính như bạch cầu, bệnh lymphoma, và đa u tủy.
- Bệnh suy tủy xương xảy ra khi tủy xương giảm hoặc không sản xuất đủ tế bào máu thuộc ba dòng máu ngoại vi.
- Bệnh thiếu máu tan máu bẩm sinh do độc tính gen huyết sắc tố.
- Bệnh rối loạn hoặc suy giảm miễn dịch.
- Bệnh rối loạn chuyển hóa.
Ngoài việc sử dụng để điều trị các bệnh lý liên quan đến máu, các nhà nghiên cứu đang tiếp tục nghiên cứu việc sử dụng tế bào gốc tạo máu từ máu cuống rốn trong lĩnh vực y học tái tạo, như điều trị một số bệnh thiếu máu cục bộ.
Ngoài ra, tế bào gốc máu cuống rốn cũng đang được nghiên cứu để ứng dụng trong việc điều trị bệnh bỏng, tiểu đường, teo cơ, liệt tủy, tai biến mạch máu não, nhồi máu cơ tim, Alzheimer, Parkinson, và có thể trong tương lai, để chống lại quá trình lão hóa.
4. Tại sao cha mẹ nên lưu trữ máu cuống rốn cho con?
Lưu trữ tế bào gốc từ máu cuống rốn là một biện pháp quan trọng để bảo vệ sức khỏe cho trẻ trong tương lai cũng như các thành viên trong gia đình. Tế bào gốc máu cuống rốn được coi là một "phao cứu sinh" cho trẻ nhờ vào khả năng độc đáo của chúng trong việc biến đổi thành các loại tế bào máu cần thiết như tế bào bạch cầu với chức năng miễn dịch, tế bào hồng cầu mang oxy cho cơ thể, và tế bào tiểu cầu hỗ trợ quá trình đông máu khi bị tổn thương.
Tế bào gốc có thể được sử dụng để điều trị nhiều loại ung thư máu, thiếu máu, thay thế tủy xương và khắc phục các bất thường do rối loạn di truyền. Ngoài ra, lưu trữ máu cuống rốn cũng có vai trò đặc biệt trong việc điều trị các bệnh nhi khoa.

Trên toàn cầu, con người đã áp dụng tế bào gốc từ máu cuống rốn để điều trị nhiều bệnh lý liên quan đến thiếu máu và các bệnh ác tính của hệ thống tạo máu như thiếu máu bất sản, thiếu máu hồng cầu liềm, và ung thư máu.
Vì thế, lưu trữ tế bào gốc máu cuống rốn là một việc rất quan trọng cha mẹ cần làm. Trong trường hợp trẻ phải đối diện với những khó khăn này, tế bào gốc từ chính máu cuống rốn của mình có thể là cứu cánh. Đồng thời, người thân trong gia đình hoặc người khác cũng có thể sử dụng tế bào gốc từ máu cuống rốn của trẻ để điều trị các bệnh lý của chính họ.
Hiện nay, quá trình thu thập máu dây rốn không gây ảnh hưởng đến vấn đề đạo đức và người tạo ra. Máu dây rốn cũng chứa một tỷ lệ khá cao tế bào gốc trung mô, có khả năng điều hòa hệ miễn dịch, điều này làm cho chúng trở nên hữu ích trong việc áp dụng cho người nhận có cùng loài.
Do đó, tế bào gốc trung mô từ máu dây rốn đóng vai trò là một nguồn điều trị tiềm năng với nhiều ưu điểm so với các nguồn tế bào gốc trung mô phổ biến khác như mô mỡ hoặc dịch tủy xương.
Đặc biệt, lưu trữ tế bào gốc từ máu cuống rốn có khả năng tái tạo các tế bào máu một cách nhanh chóng và có thể biến hóa thành nhiều loại tế bào mô khác nhau như tế bào cơ, tế bào não, tế bào gan, tế bào da, tế bào thận, tế bào tuyến tụy... Điều này mở ra triển vọng sử dụng chúng trong việc điều trị nhiều loại bệnh khác nhau trong tương lai. Vì thế, khi mới sinh ra cha mẹ nên lưu trữ máu cuống rốn cho con.
5. Lưu trữ tế bào gốc máu cuống rốn ở đâu?
Ngân hàng máu cuống rốn Vinmec là một trong những cơ sở lưu trữ tế bào gốc từ máu cuống rốn với công nghệ tiên tiến và quy trình nghiêm ngặt. Các mẫu tế bào gốc máu cuống rốn này được bảo quản trong điều kiện lý tưởng và đảm bảo quyền riêng tư cho từng khách hàng.
Với hình thức lưu trữ một mẫu hoặc hai mẫu, thời gian lưu trữ máu cuống rốn tại ngân hàng MCR Vinmec được xác định tương ứng với các khoảng thời gian như sau:
- Lưu trữ tế bào máu cuống rốn thời hạn 1 năm;
- Lưu trữ tế bào máu cuống rốn thời hạn 5 năm;
- Lưu trữ tế bào máu cuống rốn thời hạn 10 năm;
- Lưu trữ tế bào máu cuống rốn thời hạn 17 năm.
Một điểm mạnh của Ngân hàng Máu Cuống Rốn Vinmec là sự kết hợp với một Bệnh viện Đa khoa Quốc tế chất lượng cao, cung cấp đầy đủ các chuyên khoa. Quá trình thu gom máu cuống rốn được thực hiện theo quy trình khép kín và tiện lợi. Tại đây, tế bào gốc từ máu cuống rốn được bảo quản bằng hệ thống công nghệ tiên tiến nhất thế giới, BioArchive của hãng Thermogenesis.
Hệ thống quản lý tối ưu giúp đảm bảo chất lượng của tế bào gốc máu cuống rốn được bảo quản tốt trong môi trường Nitơ lỏng trong khoảng thời gian lên đến 18-20 năm. Các thông số chất lượng của mẫu tế bào gốc được xây dựng dựa trên tiêu chuẩn của FDA - tiêu chuẩn quốc tế mà hầu hết các ngân hàng máu cuống rốn uy tín đều tuân thủ.
Vinmec hiện là Hệ thống Y tế đầu tiên tại Việt Nam đã nghiên cứu và áp dụng thành công tế bào gốc trong điều trị nhiều bệnh nan y như bại não, liệt do chấn thương cột sống, xơ gan, teo đường mật bẩm sinh... Vì vậy, khi cần thiết, lưu trữ tế bào gốc máu cuống rốn sẽ được sử dụng trong điều trị bệnh bằng những phương pháp tiên tiến trong điều kiện cơ sở vật chất hiện đại, mang lại hiệu quả chữa trị cao.
Để đặt lịch khám tại viện, Quý khách vui lòng bấm số HOTLINE hoặc đặt lịch trực tiếp TẠI ĐÂY. Tải và đặt lịch khám tự động trên ứng dụng MyVinmec để quản lý, theo dõi lịch và đặt hẹn mọi lúc mọi nơi ngay trên ứng dụng.